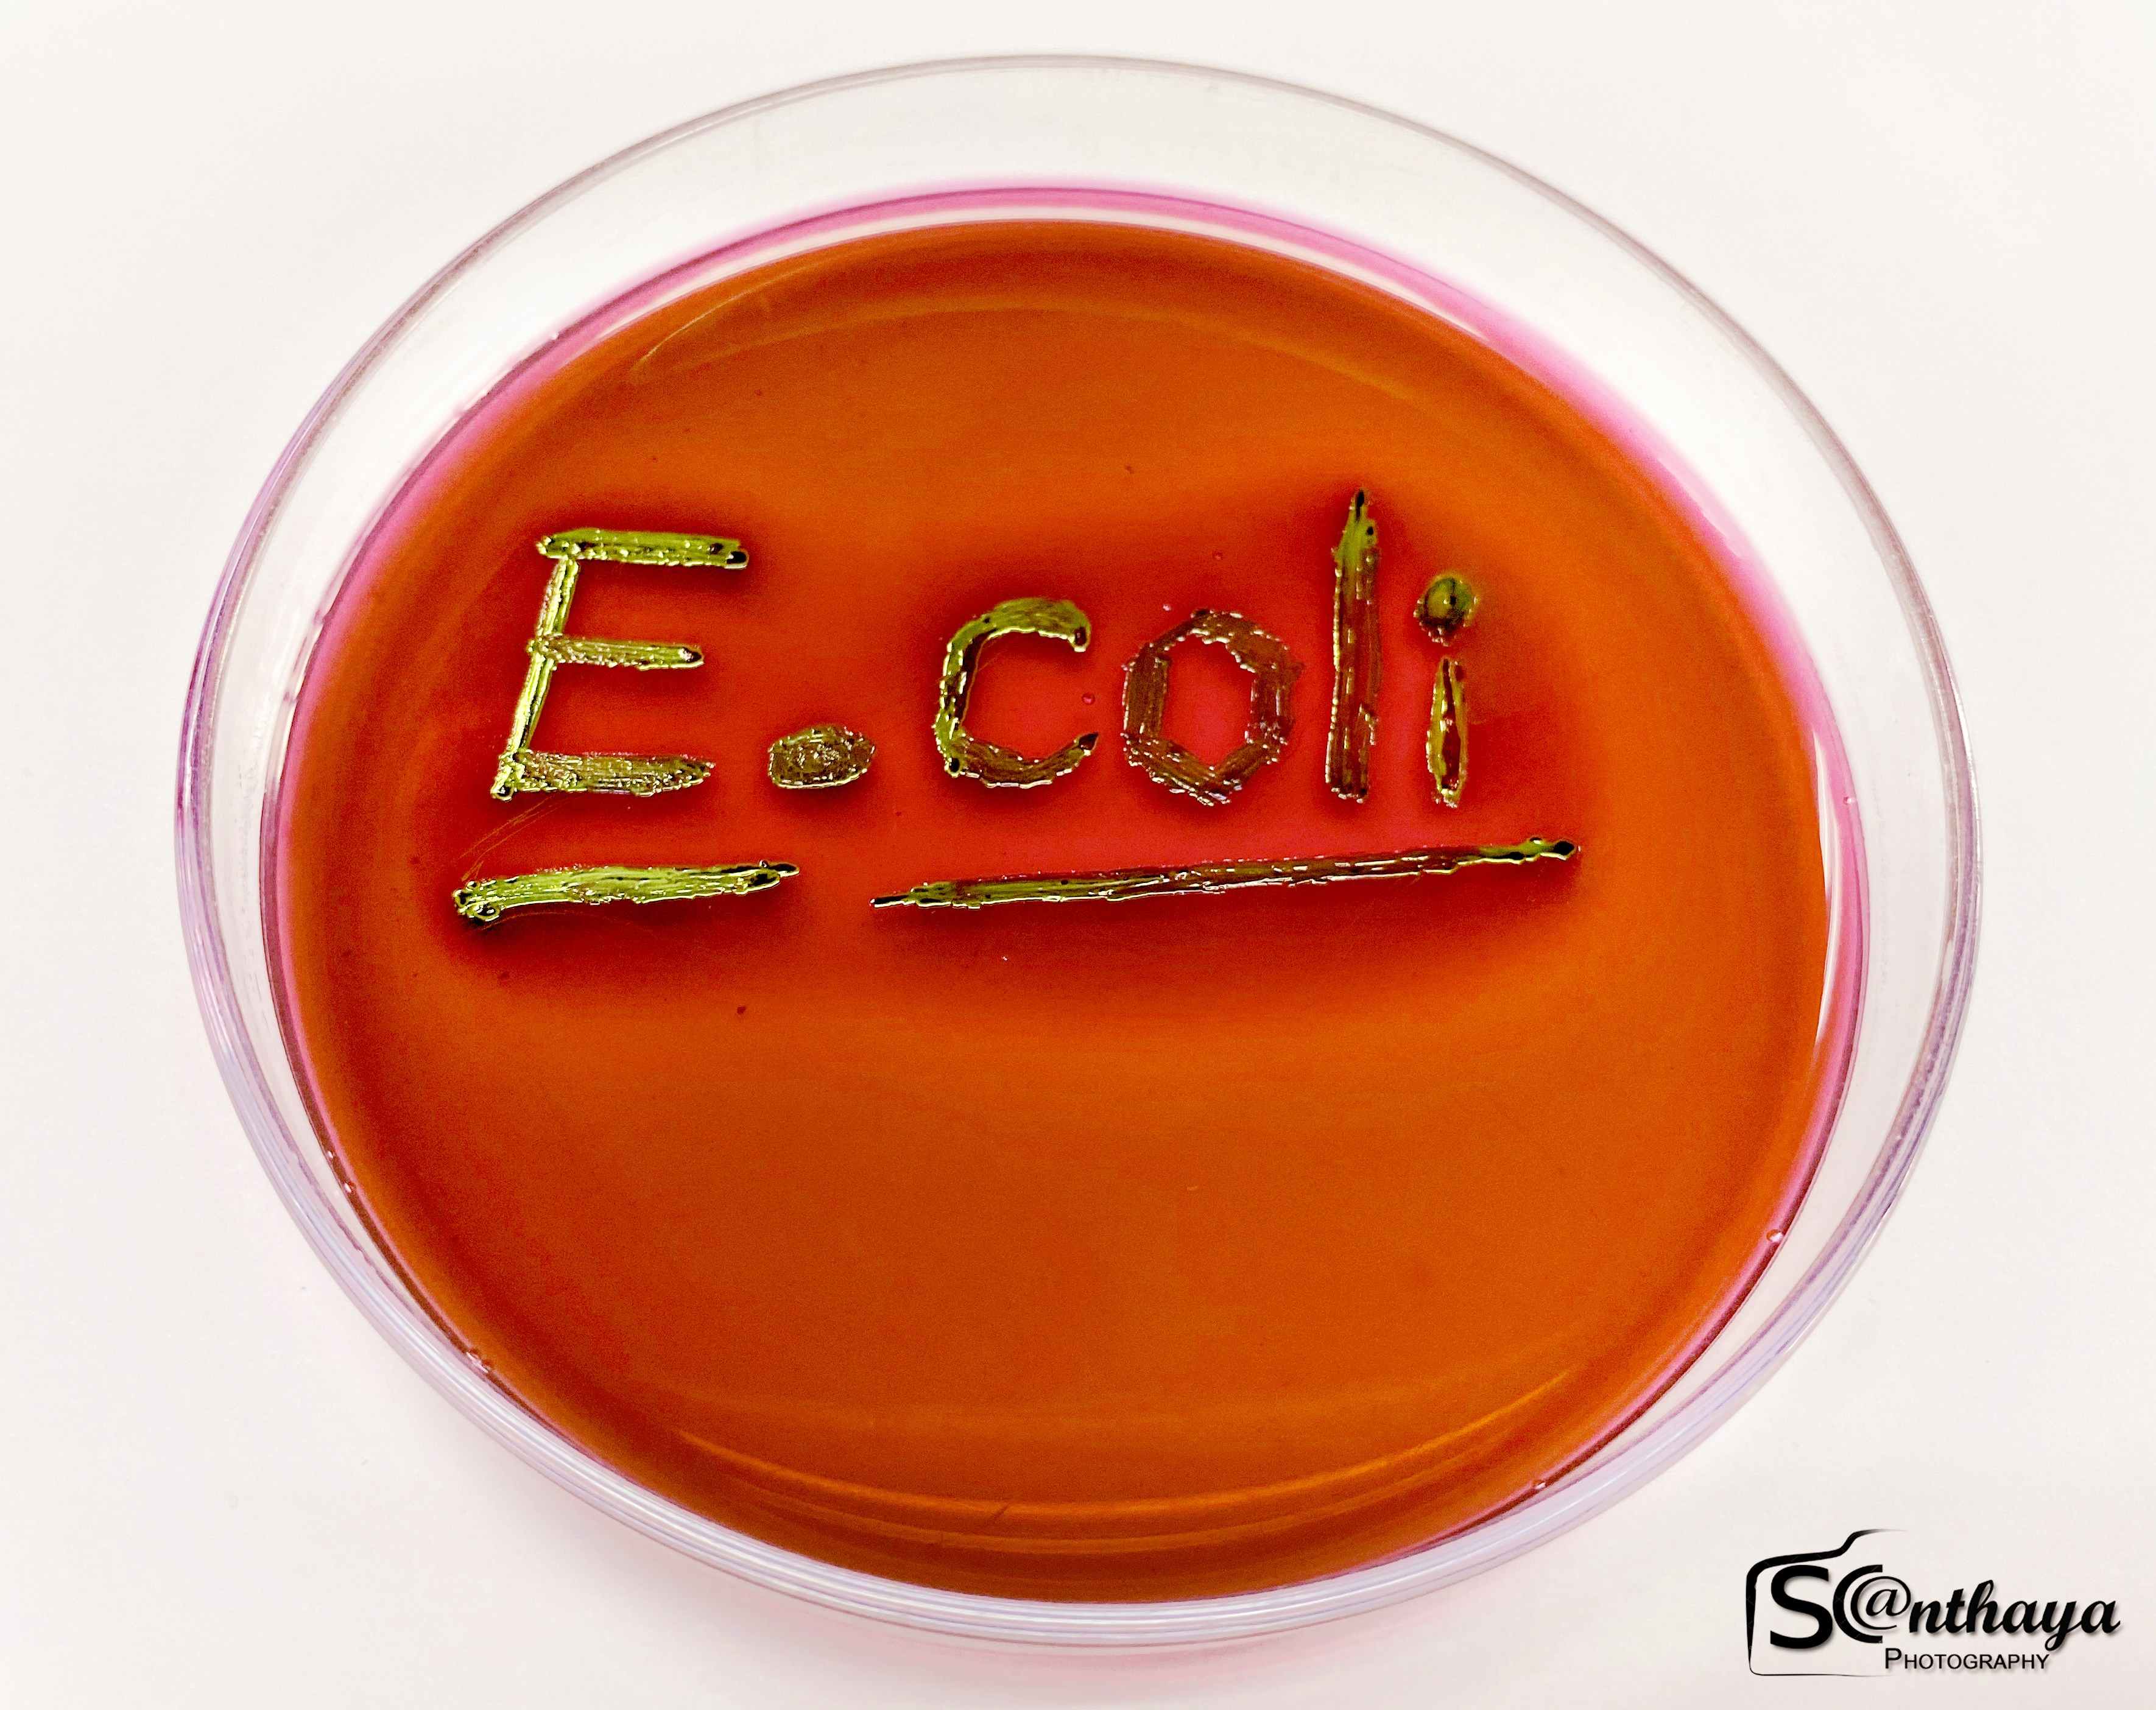

โครงสร้าง รูปร่าง การจำแนกชนิด การเจริญเติบโตและวงจรชีวิตของจุลินทรีย์และปรสิต เชื้อก่อโรคและปรสิตที่เป็นสาเหตุสำคัญของปัญหาสาธารณสุข การทำให้ปลอดเชื้อและทำลายเชื้อ และการระงับการเจริญของเชื้อโรค การเก็บตัวอย่างสิ่งส่งตรวจ ปฏิบัติการพื้นฐานทางจุลชีววิทยาและปรสิตวิทยา
- อาจารย์: 5800026 ผศ.ดร.สันธยา บุญรุ่ง